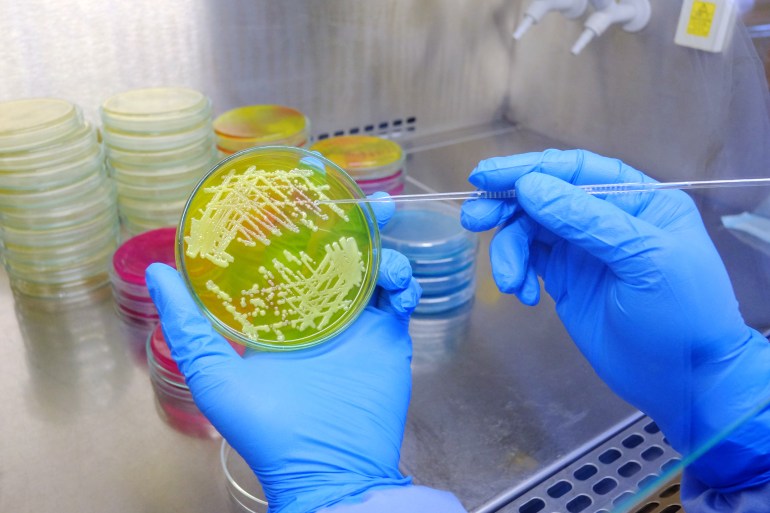
المقاومة البكتيرية للمضادات الحيوية آخذة في الارتفاع (غيتي) Scientist pick-up single colony of bacteria from medium agar plate by using disposable loop in biological safety cabinet shutterstock_1687836487

إن اختيار التخصص الدراسي أمر صعب، وبالذات للشباب وهم يهمون بالالتحاق بالجامعات والمعاهد، حيث يغدو سؤال التخصص الذي يجب اختياره للدراسة ومن ثم العمل فيما بعد سؤالا بالغ الأهمية، وبالذات مع انتشار البطالة بين عدد كبير من خريجي الجامعات في وطننا العربي.
وسجل معدل البطالة بين الشباب في الدول العربية أعلى معدل في العالم عند 28% في عام 2023، بانخفاض قدره 3.3 نقطة مئوية عن أعلى مستوى له عند 31.3% في عام 2020، ونقطة مئوية واحدة فوق مستوى ما قبل الجائحة البالغ 27% في عام 2019، وفق ما ذكرت منظمة العمل الدولية.
ويعاني الشباب الحاصلون على شهادة جامعية في العديد من دول المنطقة العربية من معدلات بطالة عالية، وفي بلد مثل الأردن -على سبيل المثال- بلغ معدل البطالة 25.1% بين حاملي الشهادات الجامعية في عام 2023 وفق بيانات دائرة الإحصاءات العامة الأردنية.
ومن هنا فإن اختيار تخصص جامعي يصمد أمام اختبار الزمن يغدو عاملا حاسما، وبالذات في ظل الثورة الصناعية الرابعة وتحدي الأتمتة والذكاء الاصطناعي والتطورات التي تحدث كل يوم على عالم الوظائف والمهن في العالم.
للإجابة على هذا التحدي سألنا في “الجزيرة نت” الذكاء الاصطناعي (أحدث نسخة من برنامج شات جي بي تي/ chatgpt4o) سؤالا محددا وهو:
ما أفضل 10 تخصصات جامعية للعمل خلال الأعوام الـ 30 القادمة؟ ثم سألناه عن الرواتب المتوقعة حاليا وبعد 30 عاما من الآن لهذه التخصصات وإليكم الإجابة:
إن التنبؤ بأفضل التخصصات الجامعية في المستقبل يتطلب النظر في الاتجاهات التكنولوجية والاقتصادية واحتياجات المجتمع.
وفيما يلي 10 تخصصات من المرجح أن تظل فعالة ومطلوبة بعد 30 عاما من الآن:
1- التخصص العاشر: التعليم
يقصد به التعليم في مجالات محددة بعينها هي العلوم والتكنولوجيا والهندسة والرياضيات (STEM focus). فمع الثورة التكنولوجية الرابعة وتطورها يوما بعد يوم سيكون هناك مجال واسع ومتزايد للمعلمين في هذه التخصصات.

وقد سألنا الذكاء الاصطناعي ليعطينا معلومات وتفاصيل أكثر حول هذا التخصص فكانت هذه الإجابة:
لا يتعلق هذا التخصص بالتدريس فحسب، بل يتعلق أيضا ببناء جيل جديد من المبدعين والمفكرين.
وتتضمن الجوانب الرئيسية: تطوير المناهج، ودمج التكنولوجيا، ومهارات حل المشكلات والتفكير النقدي.
- الرواتب الحالية والمتوقعة
تختلف الرواتب بشكل كبير بناءً على عوامل مثل الموقع الجغرافي ومستوى التعليم والخبرة والأدوار المحددة، والبلد أو الدولة التي يعمل فيها المعلم.
فراتب معلم هذه المواد في الولايات المتحدة والدول الإسكندنافية يختلف عن راتب المعلم في المنطقة العربية ودول العالم الثالث عموما لهذا استوجب التنبيه.
- الراتب الحالي (2024) لمدرسي العلوم والتكنولوجيا والهندسة والرياضيات في المدارس حتى الصف الـ12 يترواح بين 60 ألفا و70 ألف دولار في السنة.
- مدرسو التعليم العالي (الجامعات/الكليات): 70 ألفا-120 ألف دولار سنويا.
- الراتب بعد 5 سنوات (مدرسو المدارس): 65 ألفا-80 ألف دولار سنويا.
- الراتب بعد 5 سنوات (مدرسو التعليم العالي): 75 ألفا-130 ألف دولار سنويا.
- الراتب بعد 30 سنة (المدارس): 90 ألفا-120 ألف دولار سنويا.
- الراتب بعد 30 سنة (التعليم العالي): 100 ألفا-180 ألف دولار سنويا.
2- التخصص التاسع: الصحة العقلية والنفسية
بحلول عام 2030، من المتوقع أن يتفوق الاكتئاب والأمراض العقلية على أمراض القلب لتصبح أكبر مصدر للقلق الصحي في العالم.
ومن أهم عوامل زيادة هذه الأمراض المشاكل الاقتصادية مثل الديون والبطالة، وأخرى اجتماعية مثل العنف المنزلي وضغوط العيش في المدن، إضافة إلى الحروب والتدهور البيئي والكوارث.
وقدرت منظمة الصحة العالمية أنه بحلول عام 2030 ستصبح الأمراض العقلية العامل الأكثر أهمية الذي يسهم في العبء العالمي للأمراض.
ومع تزايد الوعي بقضايا الصحة العقلية، سيكون لخريجي طب النفس السريري ومختصي الصحة العقلية والأعصاب والإرشاد والتمريض النفسي دور حاسم في تقديم الدعم.
- متوسط الرواتب الحالية والمتوقعة
يمكن أن تختلف الرواتب في مجالات علم النفس والصحة العقلية بشكل كبير بناءً على عوامل مثل المستوى التعليمي والتخصص والموقع الجغرافي والدولة ونوع العمل.
فيما يلي تفصيل للرواتب الحالية والرواتب المتوقعة في 5 سنوات والرواتب المقدرة بعد 30 عاما:
- الرواتب الحالية 2024
- علماء النفس السريريون: 85 ألفا-100 ألف دولار سنويا.
- علماء النفس الاستشاريون: 70 ألفا-90 ألف دولار سنويا.
- علماء النفس المدرسيون: 70 الفا- 80 ألف دولار سنويا.
- ممارسو التمريض النفسي: 100 ألفا-130 ألف دولار سنويا.
- مستشار الصحة العقلية: 50 ألفا-65 ألف دولار سنويا.
- الرواتب المتوقعة بعد 5 سنوات (2029)
- علماء النفس السريريون: 90 ألفا-110 آلاف دولار سنويا.
- علماء النفس الاستشاريون: 75 ألفا- 95 ألف دولار سنويا.
- علماء النفس المدرسيون: 75 ألفا-85 ألف دولار سنويا.
- ممارسو التمريض النفسي: 110 آلاف-150 ألف دولار سنويا.
- مستشار الصحة العقلية: 55 ألفا-70 ألف دولار سنويا.
- الرواتب المقدرة في 30 عاما (2054)
- علماء النفس السريريون: 110 آلاف-150 ألف دولار سنويا.
- علماء النفس الاستشاريون: 90 ألفا-120 ألف دولار سنويا.
- علماء النفس المدرسيون: 85 ألفا-110 ألف دولار سنويا.
- ممارسو التمريض النفسي: 130 ألفا-200 ألف دولار سنويا.
- مستشار الصحة العقلية: 70 ألفا-90 ألف دولار سنويا.
3- التخصص الثامن: التكنولوجيا الحيوية/الهندسة الحيوية
التكنولوجيا الحيوية هو التخصص الذي يبحث في تطوير الأدوية واللقاحات وأدوات التشخيص، ويشمل ذلك الهندسة الوراثية وهندسة الأنسجة والعلاج الجيني والطب الشخصي وتطوير الأدوية وتحسين المنتجات الزراعية.
وتركز الهندسة الحيوية على تطبيق مبادئ الهندسة في المجالات الطبية والبيولوجية والزراعية، بما في ذلك تصميم وتحسين الأجهزة والمعدات والبرمجيات الطبية، والتكنولوجيا الحيوية الزراعية.

- مسارات العمل:
- عالم أبحاث: يجري التجارب ويطور منتجات جديدة.
- محلل مراقبة الجودة: يضمن أن المنتجات تلبي معايير السلامة والفعالية.
- مهندس الطب الحيوي: تصميم واختبار الأجهزة والمعدات الطبية.
- مهندس سريري: يعمل في بيئات الرعاية الصحية لإدارة التكنولوجيا الطبية.
- مهندس الميكانيكا الحيوية: يركز على ميكانيكا الأنظمة والأجهزة البيولوجية.
- الرواتب الحالية والمتوقعة
- الراتب الحالي: من 70 ألفا إلى 100 ألف دولار في السنة حسب الخبرة والمنطقة الجغرافية.
- الراتب بعد 5 سنوات: من 80 ألفا إلى 100 ألف دولار سنويا.
- الراتب المتوقع بعد 30 سنة: من 120 ألفا إلى 180 ألف دولار سنويا.
4- التخصص السابع: إدارة الأعمال
إدارة الأعمال هي تخصص متعدد الاستخدامات يؤهل الطلاب لمجموعة واسعة من الأدوار في مختلف الصناعات، وتشمل مجالات التركيز والدراسة الرئيسية على التنظيم والتخطيط والتسويق، والتحليل المالي وإستراتيجيات الاستثمار، وإدارة الموارد البشرية والعمليات، وريادة الأعمال.
- مسارات العمل والفرص الوظيفية:
- محلل أعمال
- مدير تسويق
- محلل مالي
- مدير موارد بشرية
- مدير عمليات
- مدير مبيعات
- مستشار مالي
- رائد أعمال
- الرواتب الحالية والمتوقعة
- الراتب الحالي: 60 ألفا-100 ألف دولار في السنة حسب الخبرة والمركز والمنطقة.
- الراتب بعد 5 سنوات: 70 ألفا-110 آلاف دولار سنويا.
- الراتب بعد 30 عاما: 100 ألف-150 ألف دولار سنويا.
5- التخصص السادس: تكنولوجيا المعلومات/الشبكات
تكنولوجيا المعلومات والشبكات هي مجال ديناميكي يركز على استخدام التكنولوجيا لإدارة المعلومات وتوصيلها.
وستكون المهارات في مجال تكنولوجيا المعلومات والحوسبة السحابية وأمن الشبكات حاسمة مع اعتماد الشركات بشكل متزايد على التكنولوجيا.

وتشمل مجالات التركيز والدراسة الرئيسية على:
- تصميم وتنفيذ وإدارة الشبكات، بما في ذلك الشبكات المحلية (LANs)، والشبكات الواسعة النطاق (WANs)، والشبكات السحابية.
- إدارة وصيانة أنظمة تكنولوجيا المعلومات والخوادم، وضمان تشغيلها بكفاءة وأمان.
- الحوسبة السحابية بما في ذلك كفاءة التخزين وقوة المعالجة.
- إدارة قواعد البيانات لتخزين المعلومات واسترجاعها بكفاءة.
- إدارة مشاريع تكنولوجيا المعلومات.
- مسارات العمل والفرص الوظيفية:
- مسؤول الشبكة
- محلل الأنظمة
- محلل الأمن السيبراني
- مسؤول قاعدة البيانات
- مهندس حلول السحابة
- أخصائي دعم تكنولوجيا المعلومات
- مهندس الشبكات
- مدير مشروع تكنولوجيا المعلومات
- الرواتب الحالية والمتوقعة
- الراتب الحالي: 80 ألفا-110 آلاف دولار في السنة حسب الخبرة والمنطقة الجغرافية.
- الراتب بعد 5 سنوات: 90 ألفا-120 ألف دولار في السنة.
- الراتب بعد 30 عاما: 130 ألفا-180 ألف دولار في السنة.
6- التخصص الخامس: الهندسة
تُعد المهن الهندسية ركائز أساسية في اقتصاد اليوم والغد، وقد سألنا الذكاء الاصطناعي عن أهم 5 تخصصات هندسية مطلوبة في سوق العمل خلال السنوات الـ30 القادمة فكانت الإجابة التالية:
تشمل التخصصات الهندسية الخمسة الأولى التي من المرجح أن يكون الطلب عليها مرتفعا على مدى السنوات الـ30 القادمة ما يلي:
- هندسة البرمجيات: مع النمو السريع للتكنولوجيا، سيكون مهندسو البرمجيات ضروريين لتطوير التطبيقات والأنظمة والابتكارات في الذكاء الاصطناعي والتعلم الآلي والأمن السيبراني.
- هندسة البيانات: مع اعتماد المنظمات بشكل متزايد على تحليلات البيانات لاتخاذ القرار، فإن مهندسي البيانات الذين يمكنهم بناء وصيانة البنى التحتية للبيانات سيكونون بالغي الأهمية.
- الهندسة الطبية الحيوية: يستمر قطاع الرعاية الصحية في التطور، مما يخلق طلبا على مهندسي الطب الحيوي لتصميم الأجهزة الطبية وتطوير تقنيات الرعاية الصحية وتحسين رعاية المرضى.
- الهندسة البيئية: مع تزايد المخاوف بشأن تغير المناخ والاستدامة، ستكون هناك حاجة إلى مهندسي البيئة لتطوير حلول لمكافحة التلوث وإدارة النفايات والطاقة المتجددة.
- الهندسة الميكانيكية: يظل هذا التخصص في غاية الأهمية بسبب التقدم في صناعة الروبوتات والتصنيع وتصميم السيارات، فضلا عن الابتكارات في المواد وأنظمة الطاقة.
- الرواتب الحالية والمتوقعة
تتراوح رواتب المهندسين بحسب التخصص والمنطقة الجغرافية والخبرة، ولكنها ستبقى ضمن الحدود التالية من الآن وحتى 30 سنة قادمة، حسب ما ذكر الذكاء الاصطناعي.
- الراتب الحالي: 80 ألفا-120 ألف دولار في السنة.
- الراتب بعد 5 سنوات: 90 ألفا-130 ألف دولار في السنة.
- الراتب بعد 30 سنة: 130 ألفا-180 ألف دولار في السنة.
7- التخصص الرابع: علوم البيئة
العلوم البيئية هي مجال متعدد التخصصات يركز على فهم التفاعلات بين البيئة والأنشطة البشرية، وهي تجمع بين المبادئ من مختلف التخصصات، بما في ذلك:
- علم الأحياء
- الكيمياء
- الجيولوجيا
- العلوم الاجتماعية
ومن المتوقع أن ينمو الطلب على علماء وأخصائيي البيئة مع تزايد المخاوف بشأن تغير المناخ وإدارة الموارد والتدهور البيئي.
وستكون القطاعات الصناعية المختلفة، والطاقة المتجددة والاستشارات البيئية، والوكالات الحكومية من أصحاب العمل الرئيسيين.
- مسارات العمل والفرص الوظيفية:
يمكن لخريجي العلوم البيئية متابعة العديد من المهن، مثل:
- أخصائي بيئة عامة
- أخصائي تلوث الهواء
- أخصائي النفايات المنزلية والطبية
- مستشار بيئي
- عالم في مجال الحفاظ على البيئة
- عالم أحياء الحياة البرية
- معلم بيئي
- مدير الاستدامة
- أخصائي الشؤون التنظيمية في المجال البيئي
- عالم أبحاث محلل تغير المناخ
- الرواتب الحالية والمتوقعة
- الراتب الحالي: 60 ألفا-90 ألف دولار في السنة.
- الراتب بعد 5 سنوات: 70 ألفا-100 ألف دولار في السنة.
- الراتب بعد 30 سنة: 100 ألف-140 ألف دولار في السنة.
8- التخصص الثالث: التمريض/إدارة الرعاية الصحية
ستظل مهن التمريض والمساعدين الطبيين وأخصائيي الصحة العامة ذات أهمية حيوية بسبب التحديات الصحية المستمرة، كما أن هذه المهن من المكونات الأساسية لنظام الرعاية الصحية العالمي.
- مسارات العمل والفرص الوظيفية:
- ممرض/ممرضة مسجلة (RN)
- ممرض/ممرضة ممارسة (NP)
- مختصة تمريض سريري
- معلم/معلمة تمريض
- مدير/ مديرة تمريض
- أخصائي صحة عامة مساعد طبيب
- الرواتب الحالية والمتوقعة
- الراتب الحالي: 70 ألفا-100 ألف دولار في السنة.
- الراتب بعد 5 سنوات: 80 ألفا-110 آلاف دولار في السنة.
- الراتب بعد 30 سنة: 120 ألفا-160 ألف دولار في السنة.
9- التخصص الثاني: علم البيانات/التحليلات
علم البيانات وتحليلها هو مجال سريع التطور يركز على استخراج الأفكار من البيانات لإبلاغ عملية صنع القرار ودفع إستراتيجية الأعمال، فهو يجمع بين الإحصاء وعلوم الحاسوب والخبرة في المجال لتحليل مجموعات البيانات المعقدة.
وتشمل مجالات الدراسة:
- التحليل الإحصائي
- التعلم الآلي
- تصور البيانات وتقديمها بتنسيقات مرئية
- استخراج البيانات واكتشاف الأنماط فيها
- فهم كيفية تخزين البيانات وإدارتها واسترجاعها

مسارات العمل والفرص الوظيفية:
- عالم ومحلل بيانات
- محلل استخبارات الأعمال
- مهندس التعلم الآلي
- محلل كمّي
- مهندس بيانات
- إحصائي
- الرواتب الحالية والمتوقعة
- الراتب الحالي: 100 ألف-130 ألف دولار في السنة.
- الراتب بعد 5 سنوات: 120 ألفا-160 ألف دولار في السنة.
- الراتب بعد 30 سنة: 180 ألفا-250 ألف دولار في السنة.
1- المركز الأول: تخصصات الذكاء الاصطناعي والتعلم الآلي والأمن السيبراني وتطوير البرمجيات
إن هذه التخصصات هي عصب الثورة الصناعية الرابعة، ومن المتوقع أن تنمو بشكل كبير جدا خلال السنوات الـ30 القادمة. ويعتبر تخصص الذكاء الاصطناعي والتعلم الآلي أهمها ولهذا تدرسه الكثير من الجامعات والمعاهد الحديثة كتخصص مستقل، وإن كان يتداخل بشكل واسع مع باقي التخصصات المذكورة.
- الذكاء الاصطناعي والتعلم الآلي
يشير الذكاء الاصطناعي إلى تطوير أنظمة الحاسوب التي يمكنها أداء المهام التي تتطلب عادة الذكاء البشري. وتشمل هذه المهام التفكير والتعلم وحل المشكلات والإدراك وفهم اللغة وحتى اتخاذ القرار.
أما التعلم الآلي فهو مجموعة فرعية من الذكاء الاصطناعي تركز على تطوير الخوارزميات التي تسمح لأجهزة الحاسوب بالتعلم من البيانات والتنبؤ بها بناءً عليها. وعلى عكس البرمجة التقليدية، حيث يتم برمجة القواعد صراحة، تعمل خوارزميات التعلم الآلي على تحسين أدائها مع معالجة المزيد من البيانات.
- مسارات العمل والفرص الوظيفية:
يعتبر الذكاء الاصطناعي والتعلم الآلي من المجالات السريعة النمو مع فرص عمل متنوعة عبر قطاعات مختلفة.
ويستمر الطلب على المهنيين المهرة في الارتفاع، مما يجعله مجالا واعدا لأولئك المهتمين بالتكنولوجيا والابتكار.
وفيما يلي بعض من آفاق العمل:
- مهندس الذكاء الاصطناعي
- مهندس التعلم الآلي
- عالم بيانات
- مهندس التعلم العميق
- مهندس معالجة اللغة الطبيعية
- مهندس الروبوتات
- مهندس الرؤية الحاسوبية
- عالم أبحاث الذكاء الاصطناعي مستشار أخلاقيات الذكاء الاصطناعي
- الرواتب الحالية (2024)
- للمبتدئ: 80 ألفا-110 آلاف دولار في السنة.
- الوظائف المتوسطة (خبرة متوسطة): 110 آلاف-150 ألف دولار في السنة.
- الوظائف العليا (خبرات عالية): 150 ألفا-200 ألف دولار في السنة.
- توقعات الرواتب بعد 5 سنوات (2029)
- الوظائف للمبتدئين: 90 ألفا-120 ألف دولار في السنة.
- الوظائف المتوسطة: 130 الفا-170 ألف دولار في السنة.
- الوظائف العليا: 180 ألفا-250 ألف دولار في السنة.
- توقعات الرواتب خلال 30 عاما (2054)
- الوظائف للمبتدئين: 120 ألفا-160 ألف دولار في السنة.
- الوظائف المتوسطة: 180 ألفا-240 ألف دولار في السنة.
- الوظائف العليا: 250 ألفا-350 ألف دولار في السنة.
